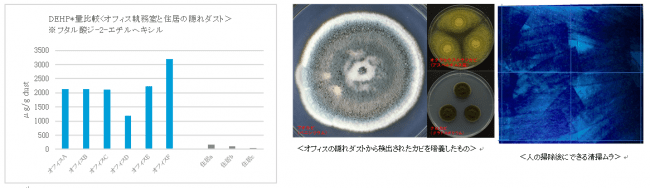

[花粉・アレルギー最新研究]オフィスに潜む「隠れダスト」の実態と課題とは

| 「隠れダスト」とは チリ、花粉、カビ、細菌等、肉眼では見えにくく、床に存在し、空気中に舞い上がりやすい人の手では取り残してしまうゴミの総称。隠れダストとは、ソフトバンクロボティクス株式会社が環境アレルゲンinfo and care株式会社との共同調査を元に独自に定義したものです。 |
環境アレルゲンinfo and care 株式会社(所在地:東京都渋谷区、代表取締役:白井秀治、以下「当社」)は、ソフトバンクロボティクス株式会社(以下、ソフトバンクロボティクス)の依頼の下、オフィスの床に潜む「隠れダスト」を明らかにするため、都内6箇所のオフィスを対象に、「隠れダスト」の実態調査を行いました。
近年、住居のダストケアに関する研究は先行する一方で、多くの社会人が家と同等、もしくはそれよりも長い時間を過ごすオフィスのダストケアに関する研究は未だ少ない状況です。そこで、健康経営などが企業の方針としても多く採用され始めている今だからこそ、オフィスの床に潜む「隠れダスト」の実態を明らかにすることは重要であるとの考えから、その対策を検討するため、調査と実験を実施しました。
調査の結果、対象となったオフィスからスギ花粉アレルゲン、ダニアレルゲン、準揮発性有機化合物(SVOC)として、フタル酸ジ-2-エチルヘキシル(DEHP)などが検出。ネコを飼育していないオフィスにもかかわらず、ネコアレルゲンも検出されました。また、全てのオフィスからアオカビ、クロカビ以外に、呼吸器に関わる健康被害が報告されている数種類のコウジカビ(アスペルギルス属)が検出され、公共スペースならではの「隠れダスト」の実態が分かりました。続いて、「隠れダスト」が床に残る要因の検討のため、人による「隠れダスト」の掃除効果を調べる実験も実施。その結果、人の掃除は“ムラ”が多く、目に見えない「隠れダスト」を取り残しやすいことに加え、掃除中にダスト粒子が舞い上がりやすい傾向があると分かりました。
実態調査の結果を受けて、日本医科大学医学部耳鼻咽喉科学教授の松根彰志氏のコメントも合わせて発表いたします。
- オフィスの「隠れダスト」を調査
準揮発性有機化合物(SVOC)、カビ、細菌、アレルゲン(スギ花粉、ネコ、ダニ)を検出。
健康被害が報告されるカビも検出。
都内6箇所のオフィスで、オフィス内の床面からダストを回収。床面に存在したダストを分析し、どのような「隠れダスト」が潜んでいるかを明らかにする調査を行いました。併せて、住居のダストも調査し、オフィスとの比較を行いました。
調査の結果、オフィスの床面からは、準揮発性有機化合物(SVOC)、ダニ、カビ、細菌、アレルゲン(スギ花粉アレルゲン、ネコアレルゲン、ダニアレルゲン)が検出。オフィスという様々な人が行き交う公共スペースならではのアレルゲンの侵入や発生の可能性が考えられます。
【準揮発性有機化合物(SVOC)】全オフィスから検出、住居に比べ高い数値。最大29倍の差も
SVOCは全オフィス、全箇所からフタル酸ジ-2-エチルヘキシル(DEHP)が検出され、住居に比べて高い値が検出されました。最も高いオフィスではホコリ1gあたり3203 μg*となり、住居の平均111 μg*の約29倍の差がありました。*μは1/100万
【カビ】住居に比べ高い数値を検出、全てのオフィスから健康被害の報告があるカビの存在を確認
オフィスと住居の違いが顕著に表れたのがカビです。調査の結果、オフィスのカビは住居に比べて多い傾向にありました。特に注視することとして6箇所のオフィス全てから、呼吸器に関わる健康被害が報告される重要な「コウジカビ(アスペルギルス属)」が多種類検出されました。その他、住居に多いとされるアオカビも全てのオフィスで検出され、そのカビ数は今回調査した住宅に比べ最大で10倍以上も多い結果でした。
【細菌】オフィスにも存在することが明らかに
細菌は住居に比べ平均的に少ない傾向でしたが、Bacillus属が多く検出され、オフィス内のダストにも細菌が存在することが確認されました。

【スギ花粉アレルゲン】12月調査にもかかわらず、オフィスへの侵入を確認
実験を行ったのは12月で、スギ花粉がまだ飛散されていないと考えられる時期ですが、1箇所のオフィスから検出*1。前の飛散シーズンでの掃除の取り残し、または早期に飛散した花粉の可能性が考えられます。今後、本格的な花粉シーズンが到来すれば、さらなる花粉が侵入し、「隠れダスト」として床に残留する可能性も考えられます。
【ネコアレルゲン】ネコの非飼育施設の全オフィスで検出。飼育者からの持ち込みの可能性も
ネコを飼育していないにもかかわらず、全てのオフィスからネコアレルゲンが検出されました。一方、同じくネコを飼育していない住居ではネコアレルゲンが検出されませんでした*2。ネコを飼育している人などからアレルゲンがオフィスへ持ち込まれ、残留した可能性が考えられます。
【ダニ、ダニアレルゲン】オフィス内のエリアによって、ダニ数に数十倍の差
ダニとダニアレルゲンは住居に比べて平均的に少ない傾向でした。同じオフィス内でも場所によってダニの最小数と最大数には数十倍の差があり、掃除しきれていない場所に隠れダストとして多く残留していることが分かりました。



スギ花粉アレルゲンはCry j 1を測定。検出限界値は<0.25 μg/g dust
*2
ネコアレルゲンはFel d 1を測定。検出限界値は<0.10 μg/g dust

| 調査概要 調査期間:2019年12月11日〜12月14日 実施条件:タイルカーペットが敷かれた都内6箇所のオフィスの執務室床から、掃除機を用いて1平方メートルあたり2分間吸引して塵を回収し各種分析測定。準揮発性有機化合物(SVOC)はGC/MS-ATD、各アレルゲンはsandwich ELISA法、ダニはワイルドマンフラスコ法、カビは塵懸濁液をM40Y培地で培養、細菌は塵懸濁液をSA培地で培養。 |
- 人の掃除では、目に見えない「隠れダスト」を取り逃しやすい。
ビジュアルクリーニングによる“清掃ムラ”が多く、約60%しか掃除できていない結果に

実験の結果、人が掃除した場合は一定の掃除効果が確認できる場所が全体の約60%しか掃除できていない結果となりました。一方で、ロボット掃除機「Whiz」の場合は全ての場所で一定の掃除効果が確認されました。被験者の掃除の様子を確認したところ、人の掃除は目に見えるごみを中心に掃除するビジュアルクリーニングのため、隠れダストを取り逃し、“清掃ムラ“が発生しやすいことが分かりました。

| 実験概要 実施日時:2019年12月16日~25日 実施条件:タイルカーペットに蛍光発光する粉体を散布し、可視光下で散布した粉体が認識できない状態で人およびロボット掃除機で清掃して、清掃後の床に紫外線照射をして発色状態を撮影した。人の掃除は目的を知らない被験者5名による平均掃除時間を算出して再現し、ロボット掃除機はプログラムしたルートを清掃した。 |
- 人が掃除する時はダスト粒子が舞い上がりやすい傾向。8倍以上の差も。

人が掃除する時の空中浮遊粉塵の粒子数を測定する実験を実施。比較実験としてロボット掃除機「Whiz」でも同様の実験を行いました。その結果、人は掃除開始直後から粒子濃度が上昇したのに対して、ロボット掃除機では粒子濃度の大幅な上昇はみられませんでした。掃除終了にかけてのピーク時の粒子濃度の比較では、人の掃除行為はロボット掃除機の約8倍以上粉塵を舞い上げていることが分かりました。人の掃除は歩行など動作が大きいため、大きな粒子でも舞上げてしまうと考えられます。
 環境制御型チャンバー内にタイルカーペットを敷き詰め、タイルカーペット上に室内塵を散布し、人とロボット掃除機による清掃行為を行い、空中に浮遊した粒子をレーザーで可視化(左)清掃時の浮遊粒子量の推移(中央)清掃時の粒子浮遊量のピーク値の比較(右)。
環境制御型チャンバー内にタイルカーペットを敷き詰め、タイルカーペット上に室内塵を散布し、人とロボット掃除機による清掃行為を行い、空中に浮遊した粒子をレーザーで可視化(左)清掃時の浮遊粒子量の推移(中央)清掃時の粒子浮遊量のピーク値の比較(右)。

| 実験概要 実施日時:2019年12月23日 実施条件:環境制御型実大チャンバー(容積30㎥、暮らしの科学研究所)にタイルカーペットを敷き、室内塵を散布して人およびロボット掃除機で清掃し、清掃時の浮遊粒子数(床上110 cm高、測定粒子径0.37-10 μm)を計測するとともに、レーザー照射による可視化された粒子を撮影した。人の掃除はあらかじめ被験者による平均掃除時間を算出し再現し、ロボット掃除機はプログラムしたルートを清掃した。 |
- 公共の「隠れダスト」には、様々なアレルゲンや微生物などが存在
広い空間のため、目に見えにくい「隠れダスト」は取り逃がしやすい
環境アレルゲンinfo and care株式会社 環境アレルゲンセンター長
(NPO法人東京アレルギー・呼吸器疾患研究所所属) 白井秀治(しらい・ひではる)

今回の調査で、公共の場所であるオフィスの隠れダストから、住居とは異なる特徴がいくつか観察されました。オフィスは住居と異なり、様々な人が土足で出入りすることが多い場所です。そのため、外部から持ち込まれるなどして住居と同様なものだけでなく、住居と異なる微生物やアレルゲンなどが検出された可能性も考えられます。これらはオフィスワーカーになんらかの影響を与える可能性があるため、対策が必要でしょう。
また、オフィスは住居に比べ空間が広いため、ビジュアルクリーニングになりやすい人の掃除では、ムラの少ない掃除が難しく、隠れダストを取り残しやすいことが分かりました。
日本のオフィスワーカーが健康に働くための対策の一つとして、今まで盲点となっていた「隠れダスト」対策は今後重要になると考えます。
- 隠れダストに存在するカビや化学物質などが、発熱や喘息、かゆみなどを起こす可能性も。
オフィスの花粉症などアレルギー症状で仕事効率低下の可能性も。

今回の調査で隠れダストに存在することが分かった、花粉、カビ、細菌、SVOC(準揮発性有機化合物)などは様々なアレルギーなどの症状を引き起こす可能性があります。
SVOC(準揮発性有機化合物)は喘息などの症状を、細菌は発熱やのどの痛みなどの症状を引き起こします。オフィスでも確認されたダニは、発熱、かゆみなどの症状を引き起こします。
カビは、肺炎・気管支炎などの症状を引き起こすことがあります。特に今回全てのオフィスで検出されたコウジカビ(アスペルギルス属)は、近年増加傾向が報告されるアスペルギルス感染症の原因となるカビです。アスペルギルス感染症には、慢性のアレルギー反応を起こし、咳、喘鳴、発熱が生じるアレルギー性気管支肺アスペルギルス症などがあり、注意が必要です。
またこれからの季節に気になる花粉などのアレルゲンは、くしゃみ、鼻水、鼻づまり、ドライアイなどの症状を引き起こすため、オフィスで働く人にとって、集中力の低下や疲れやすくなるなど、仕事の効率低下に繋がります。ネコアレルゲンは、目の激しい痒み、咳などの症状を引き起こします。調査をしたオフィスでは、非飼育環境にもかかわらず、ネコアレルゲンが検出されました。オフィスのような公共スペースでは、自分が注意していても別の場所からアレルギーなどが持ち込まれている可能性があるということは知っておいたほうが良いでしょう。
「隠れダスト」は、定期的な床の掃除をすることで、ある程度の対策は可能です。目に見えにくいため、一見キレイに見える床でも掃除を行う必要があり、さらにムラなく掃除をすることが重要になります。また、「隠れダスト」は空気中に舞い上がりやすいので、それを予防するため、マスクや空気洗浄機などの対策も有効になるでしょう。
- 【実験協力】ロボット掃除機「Whiz」について
 ©SoftBank Robotics
©SoftBank Robotics
最初に「Whiz」を手押しして清掃エリアの地図データを作成し、記憶させることで、スタートボタンを押すと記憶した地図データを基に清掃ルートを自律走行するため、清掃時の品質を一定に保つことができます。また、清掃ルート上に人や障害物が出現しても、「Whiz」に搭載された複数のセンサーが検知することで、回避しながら走行することが可能です。
詳細はこちら
https://www.softbankrobotics.com/jp/product/whiz/
このプレスリリースには、メディア関係者向けの情報があります
メディアユーザー登録を行うと、企業担当者の連絡先や、イベント・記者会見の情報など様々な特記情報を閲覧できます。※内容はプレスリリースにより異なります。
すべての画像